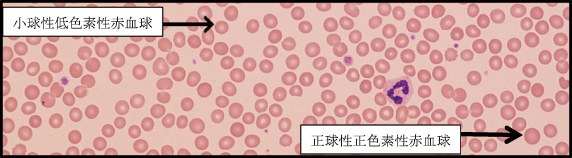

=== 随筆・その他 ===
|
| TVで見た症状と「同じ」です |
東区・郡元支部
(デイジークリニック) 武元 良整 |
|
メディアの影響は無視できず,ありがちな受診理由です。TVで見た貧血症状と「同じ」と訴えての来院が2人続きました。血液生化学検査にて1例はビタミンB12欠乏,2例目は潜在的鉄欠乏でした。
症 例 1:41歳,女性
主 訴:頭痛とめまい,手指のしびれ感,起床困難,貧血精査(フェリチン検査)希望
背 景:長男9歳と長女7歳に,卵アレルギー歴があるため,本人も数年間は乳製品を摂取していない。えびアレルギー歴あり
既 往 歴:10年前,子宮内ポリ-プ除去手術,前置胎盤処置後に輸血歴あり。今年,子宮筋腫指摘
病 歴:頭痛やめまいと手指のしびれのため,脳外科受診。精査にて脳外科的には頭痛を来すような器質的疾患なし。下痢と便秘が常で,午後睡魔が時々ある。倦怠感にて朝は起床困難,たちくらみ,口内炎そして動悸もあり。TVで低フェリチンの番組を見て同じ症状と思い検査希望で来院
末梢血検査
検査結果
RBC:461/μL,Hb:13.7g/dL,MCV(mean corpuscular volume:平均赤血球容積):88.3fL,MCH(mean corpuscular hemoglobin:平均赤血球血色素値):29.7pg,PLT(血小板数):26.7万/μL |
Hb値が13.7で貧血は否定。ところが,翌日報告の血清フェリチン値は15.0ng/mLと軽度の潜在的鉄欠乏でした(フェリチン<12が潜在的鉄欠乏の基準)1)。末梢血液像を観察すると赤血球の形態は大小不同1+あり,多染性1+でした(図1)。つまり,末梢血所見は貧血からの回復期でした。そして,後日報告の血清ビタミンB12は122pg/mL(基準値180-914pg/mL)と著明に低下していました。
臨床経過:頭痛とめまい,手指のしびれは軽度フェリチンが低下していますが,「ビタミンB12欠乏」が主原因と考えました。再来時,外来でビタミンB12の静注により翌日にしびれは消失。翌日朝の起床も容易になりました。ビタミンB12欠乏の自覚症状はたちくらみ,倦怠感・動悸・顔面蒼白・舌痛・アザができやすい・胃部不快・便秘や下痢・頭痛など多種多様です2)。問診から,お子さんのアレルギー予防のため,ご家族で乳製品摂取を極端に制限された様子。それもビタミンB12低値の原因の一つではないかと考えました。ビタミンB群は体内では合成されず,食事からの摂取が基本です。食品では乳製品(卵,ヨーグルト,チーズ),タンパク質(赤みの肉,豆腐,サーモン,牡蠣そしてレバー)に多く,海藻類では海苔にも多いとされます。ただし,慢性の下痢や炎症性腸疾患があればビタミンB12の腸からの吸収は極端に影響を受け,ビタミンB12不足となります。
症 例 2:29歳,女性
主 訴:めまい,たちくらみ。TVで見た「かくれ貧血」と同じ症状と訴えて来院。貧血検査希望
背 景:長女5歳と長男3歳育児中,妊娠中は貧血の指摘なし
既 往 歴:地震のあとから過呼吸があり,自律神経障害と診断され安定剤内服継続も改善しない
末梢血検査
検査結果
RBC:444/μL,Hb:13.1.g/dL,MCV(mean corpuscular volume:平均赤血球容積):89.4fL,MCH(mean corpuscular hemoglobin:平均赤血球血色素値):29.4pg,PLT(血小板数):22.7万/μL |
翌日報告の血清フェリチン値は7.7ng/mLと鉄欠乏を示唆します(Hb>12.0かつフェリチン<12が潜在的鉄欠乏の基準)1)。つまり,潜在的鉄欠乏です。鉄剤治療を開始しました。
まとめ
症例1は,血液生化学検査からビタミンB12欠乏(ビタミンB12=122)による「頭痛やめまい,手指のしびれ」と診断。血清ビタミンB12測定が有用な症例でした。問診にて食事内容まで聞き取り,多彩な症状から典型的なビタミンB12欠乏と診断しました。
症例2は低フェリチンにて「潜在的鉄欠乏」と診断。この「めまい・たちくらみ」などの症状が「かくれ貧血」という言葉でTVでは紹介されているようです。鉄剤内服困難で静注治療中。
低フェリチンと貧血との関連:今回2症例ともにHb値が正常範囲でした。TVを見て貧血症状だと感じて受診されました。デイジークリニック5年間に低フェリチンの症例は526例,その中でHb値が12.0未満の貧血症例は446例。つまり,低フェリチン526例中84.7%は明らかな貧血です。Hb12.0以上で低フェリチン症例は15.3%となります。少ない頻度ですが,貧血改善中の症例がTVを見て来院される事があると痛感した2症例でした。なお,2例ともに妊娠・出産・育児・勤務と切れ目のない生活の中で体調がすぐれないという共通点がありました。妊娠中,出産後,育児中に「倦怠感,めまい,たちくらみ」があれば貧血除外のため貧血の早期から減少するフェリチンの値や「たちくらみ,倦怠感,動悸,頭痛」を来すビタミンB12低下の有無を確認する事は有用と思われました。
文 献
1.張替秀郎:鉄代謝と鉄欠乏性貧血-最近の知見-,日内会誌 104:1383-1388.2015
2.武元良整:健診で貧血を指摘されて(1)~2年間,自覚症状のなかった鉄欠乏性貧血~鹿児島県医師会報 平成28年9月号:65-67.2016
|
図1 末梢血液像:RBC形態は大小不同1+あり,多染性1+
(末梢血液画像は鹿児島市医師会臨床検査センター血液検査室へ依頼し撮影していただきました) |

|
|
このサイトの文章、画像などを許可なく保存、転載する事を禁止します。
(C)Kagoshima City Medical Association 2016 |